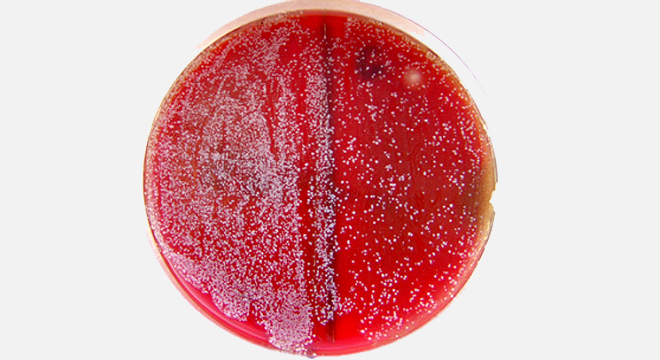

In der Scheidenschleimhaut ist eine grosse Menge verschiedener Bakterien und Pilze angesiedelt, die in der Regel friedlich miteinander auskommen und ein besonderes "Milieu" bilden.
Bei der gesunden, geschlechtsreifen Frau überwiegen im Scheidenmilieu die so genannten Laktobazillen oder Milchsäurebakterien. Diese haben eine wichtige Aufgabe: Aus Glycogen (Stärke), das in den Zellen der Scheidenschleimhaut vorhanden ist, bilden sie Milchsäure. Das dadurch entstehende saure Milieu behagt krankmachenden Bakterien und Pilzen in der Regel wenig und sie werden in ihrem Wachstum gehemmt. Durch bestimmte Faktoren kann dieses Gleichgewicht gestört werden und die Pilze können wachsen.
Die Hälfte aller Frauen erkrankt mindestens einmal in ihrem Leben an einer Pilzinfektion.